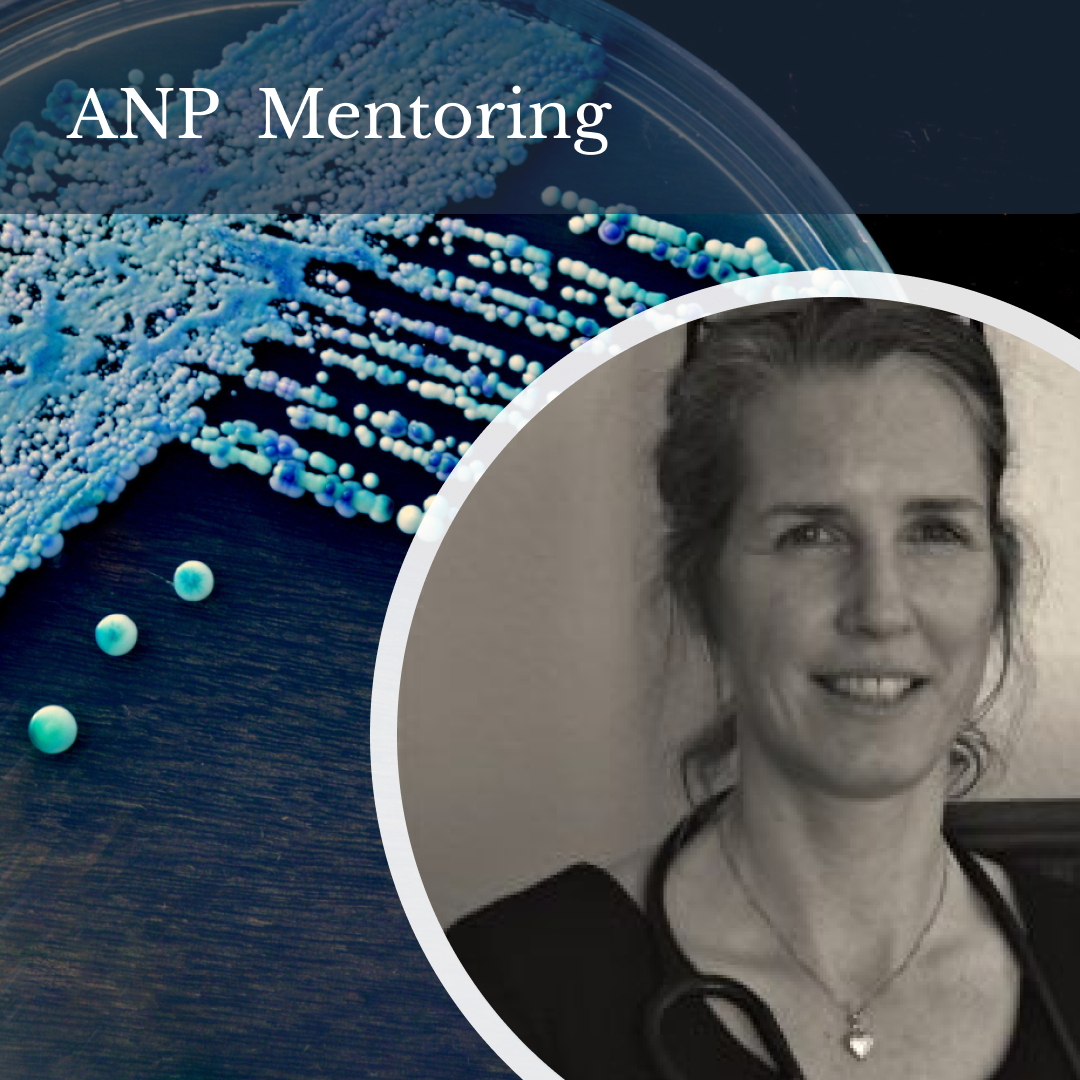
microbiome site

Naturopathic Nutritional Therapist Membership
The ANP welcomes practitioners, students and non-practising naturopathic nutritional therapists. We provide a wide-range of support for our members including practitioner training, mentoring, business advice and access to our Herb-Drug-Nutrient Interactions database.
The Naturopathic Approach
The ANP is the UK’s largest naturopathic association.
We provide practitioner training and support to ensure our members succeed in clinical practice.
The ANP promotes a naturopathic approach to nutrition. The Naturopathic Nutritional Therapist never prescribes supplements to ‘treat’ a symptom but looks at the underlying cause and the constitution of a client.
Our members must have a minimum of 200 clinical hours during their training and are required to meet 30 hours of continuous professional development annually to stay abreast of the latest developments in the field of natural therapies and adhere to the ANP Code of Ethics.
Benefits of Joining the ANP

GNC Listing
- Your listing on our practitioner directory service to help new patients find you.
- MANP after your name and use of the ANP logo and Nutritional Therapist Title.
- A membership certificate to display wherever you consult.
- A Continuing Professional Development scheme including monthly nutrition webinars and also access to monthly webinars covering herbal medicine, health coaching and naturopathy.
- Access to our Learning Hub with over 100 webinars on a wide-range of topics to support your clinical practice.
- Discounted access to the ANP Summit.
- Up-to-date news and information on current laws and regulations affecting the profession and representation at parliamentary meetings.
- Membership of the General Naturopathic Council (GNC) and listing in the GNC practitioner directory.
- Access to Efficasafe Herb-Drug-Nutrient Interaction database.
- Member special offers and discounts with suppliers.
- Member support from our head office.
- Private Community Facebook Group.
- Discounted Insurance with Balens.
- Templates to help you set up your practice including Data Protection Policy and Terms of Engagement.
Upcoming Events & Mentoring

Your Home, Your Health: A Certified Workshop in Surveying the Impact of EMF’s and Geopathic Stress on the Home

Thyroid Practitioner Mentoring with Dr Sarah Myhill
Latest from the Learning Hub

Using Mushrooms for Cognitive Function

Dental Health & Systemic Disease
Mastering Mycotoxins in Illness
The ANP Facts & Figures
3000 +
Join the UK’s largest association with a community of over 3000 naturopathic practitioners.
1
Annual summit with expert practitioners sharing latest developments in naturopathy.
7
Grow your network across 7 different types of registered naturopathic health professionals.
100 +
Access over 100 hours of practitioner training in our on-demand learning hub.
Efficasafe Interactions Database.
Created for practitioners, by practitioners.
Evidence based – Clinic orientated – Unbiased
The EfficaSafe interactions database is now included with ANP membership.
EfficaSafe is a powerful clinical tool for safely integrating herbs and nutrients with pharmaceuticals, complete with detailed
monographs, monitoring tools and much more.
ANP members can use Efficasafe to optimise the efficacy of nutritional and herbal protocols for safe integrative care.
- Efficasafe is a groundbreaking, evidence-based clinical decision support platform designed to help healthcare practitioners make safe, informed therapeutic decisions.
- With a database of over 105,000 interactions backed by more than 70,000 studies, Efficasafe allows practitioners to instantly cross-check drug-drug and herb/nutrient-drug interactions, ensuring a higher level of clinical safety and effectiveness.
- Efficasafe is completely independent. Their data is free from advertising or industry sponsorship, ensuring unbiased, practitioner-focused guidance.
- Normally £156/year, Efficasafe is provided at no additional cost — a valuable benefit that enhances your practice and supports professional excellence.
Why choose the ANP
We bring with us 25 years of expertise in supporting over 3,000 practitioners
- Most comprehensive online CPD programme in the UK.
- Access to expert webinars covering a range of approaches including health coaching, naturopathy, herbal medicine and more.
- Monthly nutrition webinars.
- Regular in-person events.
- Use of practitioner friendly Efficasafe Interactions Database.
- Recognised Naturopathic Nutritional Therapist title.

How to Register As a Nutritional Therapist
| Membership Type | |||
| Features | Non-Practicing Member (£85) | ANP Full Member (£140) | ANP (Student) (£45) |
| Monthly CPD lectures (online and in person) | |||
| Access to ANP Contraindication Database | |||
| Registration with the GNC* | |||
| Discount on Insurance | |||
| Free Practitioner Directory | |||
| Access Mentoring Programme | |||
| Government Representation | |||
| Training Videos | |||
| ANP Discounts | |||
| Free Practitioner Listing GNC | |||
| JOIN NOW | JOIN NOW | JOIN NOW | |



















